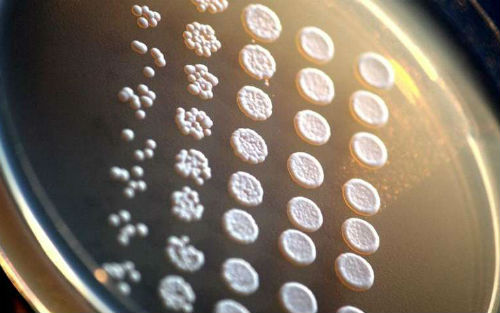

科学家们发现,虽然人类和酵母已经在不同的道路上进化了十亿年,但我们之前的相似之处仍然非常多。他们将四百多个人类基因分别插入到酵母细胞中,发现大约50%的基因能够行使功能让这种真菌存活下来。这项研究于五月二十一日提前发表在Science杂志的网站上。
“这很神奇,”印第安纳大学的进化生物学家Matthew Hahn评论道。“这意味着,即使经过十亿年的分歧,同样的基因仍旧行使同样的功能。”
众所周知,人类和酵母存在一定的分子相似性。三分之一的酵母基因可以在人类基因组中找到对应的版本。酵母和人类的对应蛋白,在氨基酸序列上平均重叠32%。
人类和酵母的共享基因引起了德克萨斯大学系统生物学家Edward Marcotte的兴趣。酵母是没有血液的单细胞生物,但它们携带着负责脊椎动物新血管生长的基因,这些基因帮助酵母应答压力。“我们想知道酵母和人类基因在功能上的相似程度,”Marcotte说。
他和研究团队系统性分析了,人类基因是否能够在酵母中起作用。研究人员选择了414个决定酵母存活的基因,比如说控制代谢和处理废物的基因。他们将酵母基因关闭或者去除,然后送入相应的人类基因。如果酵母能够在培养皿上生长,就说明人类基因成功行使了酵母基因的功能。
研究人员发现,有176个人类基因可以让酵母存活下来。Marcotte指出,四百多个酵母基因中大约一半能被人类基因代替,这些人类基因在酵母中仍旧能够行使功能,它们是酵母和人类的共同祖先留下的遗产。
那么这些基因具有怎样的特点呢?研究人员评估了一百多种可能的影响,从基因长度到蛋白质丰度。他们发现,人类基因是否能够替代酵母基因,并不取决于DNA序列的相似程度。在一组密切合作的人类基因中,要么大多数都能替代酵母基因,要么大多数都不能替代。举例来说,在促进DNA复制的一个通路中,任何基因都不能替代。但在制造胆固醇的分子通路中,几乎所有基因都能够替代。
这项研究只说明配备了人类基因的酵母可以生存,并未展示这些酵母能否与天然酵母竞争,美国国家生物技术信息中心的进化生物学家Eugene Koonin评论道。不过这项研究有力地证明了一个曾经受到质疑的观点:不同生物的对应基因具有类似的功能。
Marcotte认为人们应当进一步利用酵母进行研究。过去研究者们一般是在酵母细胞中插入单个基因,其实可以引入一组自己感兴趣的基因,这将有助于开发新药物或者研究疾病中出现问题的分子回路。
